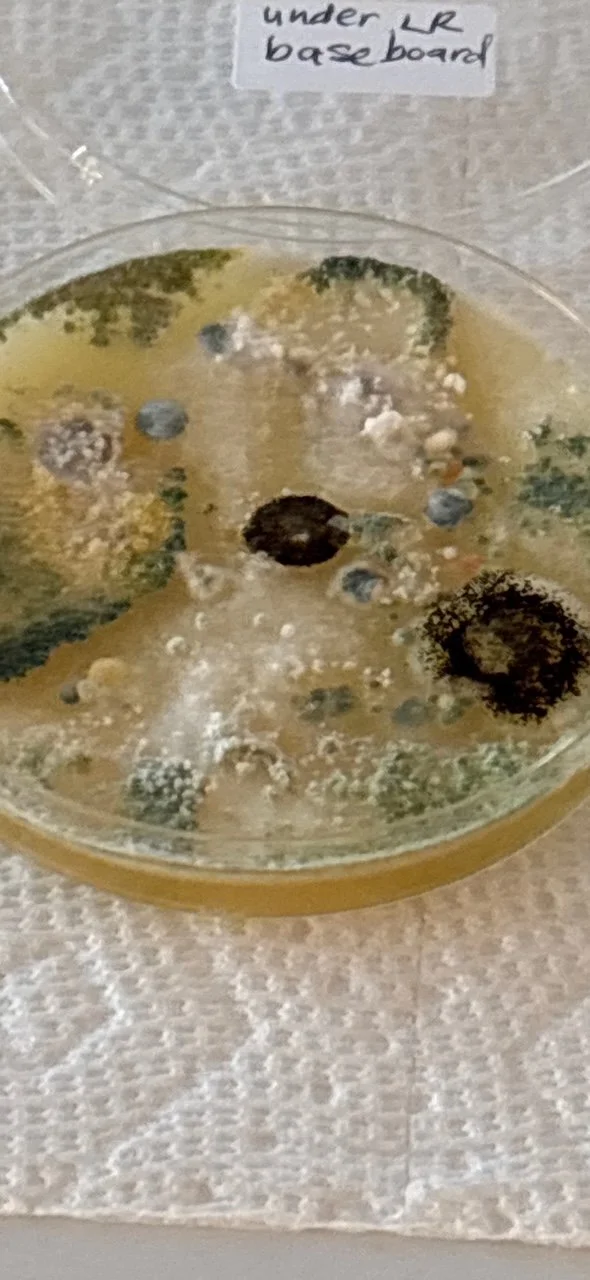
IMG_1873.JPG

Our purchase of a TriPointe townhome has turned into two years of mold, leaks, poor workmanship, incompetence and unending frustration.
Our dream was to retire in a low maintenance, high quality home.
Within a few months, as humidity became an issue in the home, mold began to appear.
We’ve been through four mold remediations, forcing us out of our home for over five months.
Most recently, roof leaks were discovered. Large sections of our roof have needed to be replaced.